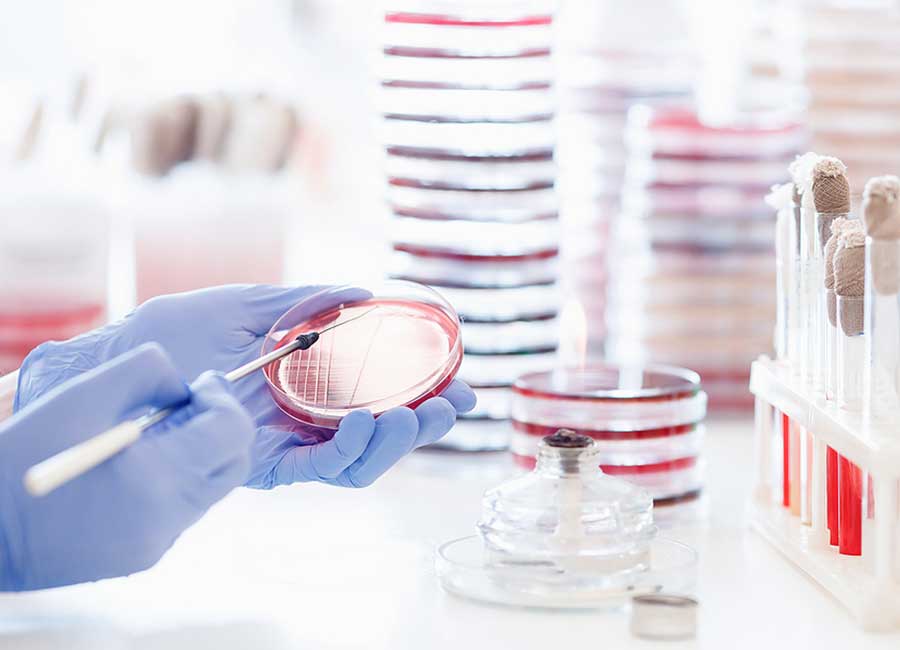
Microbial

What We Offer
Microbiological testing is a key component of any successful quality program. Our analysis can identify contaminations in your merchandise, determine shelf life of your product before degeneration, evaluate various types of environment for storage compatibility, and more. For food and beverage products, microbiological testing can help detect toxic pathogens like Listeria, Salmonella, E. coli, and other microorganisms that cause food to spoil like yeast or mold. A microbiological testing program can unearth hazardous microbes before they have a chance to reach customers and potentially cause illnesses and damage to a brand’s reputation.
Microbiology Testing Options
Bia Diagnostics has the equipment, the experience and the subject matter experts to personalize a microbiological testing program based on your specific needs. In our state-of-the-art laboratories, our microbiology facilities are strategically assembled to block unwanted pathogens from contaminating your test results by utilizing specialized filtration systems to provide you with reliable, accurate readings. We offer a variety of microbiology testing options to best fit your needs, including:
- Contamination testing (growth-bacteria, mold, fungus, other micro-organisms)
- Shelf-life testing
- Stability testing
- Aerobic Plate Count testing
- Marketing claim substantiation